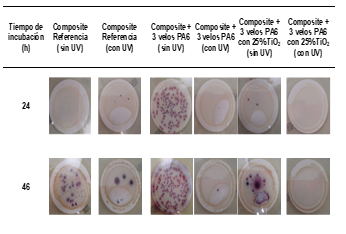

1 Introducción
Los composites epoxídicos de fibra de carbono han ganado una atención sustancial en las últimas décadas. Entre las razones de su éxito, cabe destacar su bajo peso, alta rigidez y resistencia. Sin embargo, la falta de tenacidad a la fractura, debida a la fragilidad de la matriz epoxi y la escasa resistencia a la delaminación, que podría provocar un fallo inesperado del material compuesto, han sido la principal desventaja que ha limitado su uso por falta de fiabilidad a largo plazo [1].
En bibliografía, se han empleado diversas estrategias para mejorar la resistencia a la deslaminación de estos materiales, como incorporar compuestos tenaces o termoplásticos a la resina, que sean inicialmente inmiscibles en ella o que separen en fases durante el curado. Sin embargo, la adición de estos compuestos podría conllevar una disminución de las propiedades mecánicas en el plano del composite, un mayor coste y peso [2]. Más recientemente, se han empleado nanopartículas ya que debido a su alta rigidez y resistencia teóricas, podrían aumentar la resistencia a la fractura y la energía en el inicio del crecimiento de grietas en los composites. La principal desventaja de incluir estas nanopartículas es la dificultad para obtener una dispersión homogénea de las mismas en la resina. Además, el aumento de la viscosidad que surge de la adición de la resina también podría reducir dramáticamente la capacidad de procesado de estos composites [3]. En los últimos años, se está empleando un método que tiene potencial para superar estos inconvenientes, que consiste en la incorporación de un entramado de nanofibras termoplásticas entre las capas de refuerzo de fibra antes del procesado del composite. Estos entramados pueden ser incorporados como un tejido en el composite, con lo cual no se aumenta la viscosidad de la resina y se solucionan los problemas de dispersión que presentan las nanopartículas. Además, debido a su dimensión en la macroescala, no hay riesgos para la salud involucrados en la producción y el uso de estos velos de nanofibras.
La tecnología de electrospinning ofrece la posibilidad de preparar estos velos de una forma sencilla y escalable y además, de incluir cargas dentro de las nanofibras, que pueden mejorar sus propiedades mecánicas o darles propiedades diferentes. La incorporación de nanopartículas metálicas o carbonosas eléctricamente conductoras, como por ejemplo los las nanofibras de carbono o nanocables de plata, puede además producir velos de nanofibras eléctricamente conductores o antibacterianos. La incorporación de estos velos en los materiales compuestos ha mostrado que puede contribuir sustancialmente a la ductilidad y tenacidad a la fractura de los composites, siendo esta mejor dependiente tipo de material del que estén hechas las nanofibras y de sus propiedades intrínsecas. Sin embargo, la posibilidad de obtener composites funcionales basados en la incorporación de nanofibras funcionales ha sido poco estudiada.
El presente trabajo estudia el efecto de la incorporación de velos electrohilados de nanofibras de poliamida 6 modificadas con nanopartículas de TiO2 no sólo en las propiedades mecánicas de los composites epoxídicos de fibra de carbono, sino también en las propiedades funcionales de los mismos. Los velos de nanofibras se incorporan en diferentes posiciones del laminado como estructuras independientes. Para investigar las propiedades mecánicas de los compuestos reforzados con velos, se realizaron ensayos de flexión, análisis mecánico-dinámico y tenacidad a la fractura en modo I y modo II. La propagación de la grietas en las muestras se estudió mediante microscopía electrónica de barrido. Además, se han analizado las propiedades antibacterianas de los composites frente a la Escherichia coli (E. coli) y otras bacterias coliformes.
2 Materiales y métodos
2.1 Materiales
La resina epoxídica, Epikote 828, ha sido suministrada por Momentive y tiene un peso equivalente de 182–190 g / equiv y una relación de hidroxilo / epoxi de 0.03. El agente de curado, 4,4'-diaminodifenilmetano (DDM), es una amina aromática tetrafuncional sólida con un peso molecular de 198 g / mol y ha sido suministrado por Alfa Aesar. Para la preparación de las nanofibras electrohiladas, se han utilizado pellets de PA6 Ultramid® B24 N 03 de BASF SE. Para la fabricación de los velos modificados con nanopartículas, se han utilizado las nanopartículas AEROXIDE® TiO2 P25 suministradas por Evonik. Estas nanopartículas tienen un tamaño de partícula primaria de 21 nm y un área de superficie específica (BET) de aproximadamente 50 m2 / g. Se ha empleado un tejido de fibra de carbono bidireccional con 200 g/m2 de HT3k de SP Systems.
2.2 Preparación de muestras
El desarrollo y la caracterización de las nanofibras de PA6 modificadas con 25% en peso de nanopartículas de TiO2 se ha ha reportado previamente [4]. La caracterización mostró que las nanopartículas de TiO2 se distribuyen homogeneamente en la superficie de las nanofibras y proporcionan una excelente actividad fotocatalítica a las nanofibras cuando son irradiadas por radiación UV, eliminándose la bacteria E. coli y otras bacterias coliformes después de 24 h de contacto.
Para el estudio, se han preparado composites conceptuales formados por dos capas de tejido de fibra de carbono posicionadas a 0 °. Los velos se han colocado siguiendo dos esquemas: sólo en la región interlaminar (esquema 1) o en la región interlaminar y también en las capas externas del material compuesto (esquema 2). Los composites se han prepado mediante moldeo por infusión. Para ello, la resina epoxi y el endurecedor se mezclaron en relación estequiométrica durante 10 minutos a 80 ºC con agitación vigorosa. La resina líquida se infusionó a través de todo el laminado, observando un ligero aumento en el tiempo de infusión de la resina para los composites con velos de PA6 modificados con 25% en peso de TiO2. También en la configuración con tres velos, el proceso de infusión se ha observado más lento. Los materiales compuestos de fibra de carbono se curaron a una temperatura de 90 °C durante cuatro horas, asegurando que los velos no se funden durante el curado de la resina. La incorporación de velos no afectó a la cinética de curado del composite. Los materiales compuestos resultantes se cortaron a las dimensiones requeridas para los diferentes análisis experimentales. Para los ensayos de fractura (modo I, modo II), se prepararon composites con 14 capas de fibra de carbono y un velo interlaminar en el eje central, para seguir las dimensiones requeridas en el estándar AITM 1.0005.
2.3 Métodos de caracterización
Los velos de nanofibras han sido caracterizados por microscopía electrónica de barrido (SEM), espectroscopía infrarroja de transformada de Fourier (FTIR), análisis termogravimétrico (TGA) y mediciones de peso, en un trabajo previo [2]. Además, se ha evaluado su actividad fotocatalítica bajo radiación UV contra un contaminante orgánico modelo, Remazol negro B (C.I. reactivo negro 5), y contra la E. coli y otras bacterias coliformes (ISO 7704:1985).
Las propiedades mecánicas de los composites se han caracterizado mediante medidas de análisis dinámico mecánico térmico (DMTA), análisis de flexión en tres puntos y medidas de tenacidad a la fractura Modo-I y Modo-II. Además, se ha empleado microscopía SEM para investigar las secciones transversales después del análisis flexión y la prueba de fractura en modo II de los composites; y se han analizado las propiedades antibacterianas de los composites con el mismo método empleado para los velos.
3 Resultados y discusión
3.1 Propiedades mecánicas
El análisis de DMTA se ha utilizado para evaluar la rigidez elástica y la amortiguación (disipación de energía) de los composites. En la figura 1 se muestra la evolución del módulo de almacenamiento (E’) y la tan δ con la temperatura de los compuestos reforzados con uno y tres velos de nanofibras de PA6 y con uno y tres velos de nanofibras modificadas con 25% de TiO2.
Se observa que el valor de E’ en la zona vitrea (bajas temperaturas) es menor para los composites modificados con velos, pero se debe considerar que la resina no está completamente curada a esta temperatura. En cuanto a tan δ, se observan dos picos. El primero por encima de 100 ºC está relacionado con el proceso de curado de los composites a 90 ºC. A medida que aumenta la temperatura, la reticulación continúa y se obtiene un segundo pico por encima de 150 °C, que corresponde a la Tg∞ del sistema. La presencia de los velos no parece tener una clara mejoría en los valores de Tg∞, pero los sistemas modificados con TiO2 parecen presentar un pico más amplio de Tg∞ como consecuencia de una reticulación más heterogénea, debido a la presencia de nanopartículas.
Los valores de resistencia a la flexión y deformación de los composites se muestran en la tabla 1. Como era de esperar, no se observó delaminación en los composites durante los ensayos. Todos los composites modificados con velos presentaron valores de deformación similares, con un claro aumento en la resistencia a la flexión con respecto a los composites de referencia. Para los compuestos modificados con un velo entre las capas de fibra de carbono, se observó un aumento de la resistencia a la flexión del 19,7% y del 24,6% para el composite con un velo de PA6 y modificad con 25% de TiO2, respectivamente. Siendo el espesor de los velos muy similar, 11 μm para el no modificados y 20 μm para el modificado, el aumento de la resistencia a la flexión se ha atribuido a que la presencia del velo previene la propagación de la grieta a través de la matriz epoxídica [1]. Los valores de resistencia de flexión obtenidos indicaron que la presencia de nanopartículas de TiO2 en los velos no afectó significativamente a las propiedades de flexión de los compuestos [5].
| Muestra | σmax (MPa) | Δσmax (%) | δmax (%) |
| Referencia | 375,5±33,2 | 2,2±0,2 | |
| 1velo PA6 | 449,5±10,8 | 19,7 | 2,1±0,0 |
| 3 velos PA6 | 415,4±23,8 | 10,6 | 2,1±0,2 |
| 1velo PA6 + 25 % TiO2 | 468,1±32,5 | 24,6 | 2,2±0,2 |
| 3 velos PA6 + 25 % TiO2 | 411,5±25,4 | 9,6 | 2,1±0,1 |
El comportamiento de fractura de los composites se analizó a través de ensayos Modo-I y Modo-II en muestras con 14 capas de tejido de fibra de carbono y un velo en la zona media. Los resultados experimentales se presentan en la figura 2 y en la tabla 2. Tanto la fuerza como los valores de energía mecánica se han normalizado a la anchura de la muestra. Después de una caída inicial en la carga para desplazamientos bajos para algunos de los composites, que se ha asociado a un pre-crack inducido artificialmente por el proceso de preparación de muestra, los valores de carga de los composites con el velo de PA6 sin modificar y modificado con 25% de TiO2 son superior con respecto a la referencia. Esta tendencia se confirma en la energía mecánica calculada mediante la integración del diagrama de desplazamiento de carga. La presencia del velo en la interfaz de apertura de grietas mejora la energía mecánica que se absorbe durante la propagación de las grietas. Además, los valores de GIC para ambos compuestos con velos fueron mayores que para la referencia, aproximadamente el 20% y el 14% para los composites con PA6 sin modificar y modificado con 25% de TiO2, respectivamente. Sin embargo, la presencia de las nanopartículas de TiO2 no parece mejorar los resultados obtenidos con el velo de PA6 no modificado, sino que más bien las propiedades se mantienen.
| Muestra | Energía (J/m) | Δ% | GIC (J/m2) | Δ% |
| Referencia | 62,7 | 389±12,8 | ||
| 1velo PA6 | 68,1 | 8,6 | 466±72,9 | 20,0 |
| 1 velo PA6 + 25 % TiO2 | 70,2 | 12,0 | 444±46,1 | 14,0 |
En la figura 3 y en la tabla 3 se muestran los resultados experimentales de los ensayos de tenacidad a la fractura en modo II de los composites. Los valores de fuerza se han normalizado a la anchura de la muestra. Los velos no influyen en la estabilidad de los composites; por lo tanto, la parte lineal inicial de las curvas era similar. Sin embargo, el efecto del velo en la capacidad de carga es visible tan pronto como la grieta comienza a propagarse. Comparando los valores de GIIc, se observa un 4% de mejora para el composite con el velo de PA6 modificado con 25% de TiO2 respecto a la referencia. Parece que las nanopartículas de TiO2 tienen una pequeña influencia en la dureza de la fractura del compuesto.
| Muestra | GIIC (J/m2) | Δ% |
| Referencia | 2.536±257 | |
| 1velo PA6 | 2.544±304 | 0,28 |
| 1 velo PA6 + 25 % TiO2 | 2.636±124 | 3,95 |
3.2 Propiedades antibacterianas
La eficiencia de los velos de nanofibras de PA6 modificas con 25% de TiO2 ha sido previamente demostrada para la eliminación de E. coli y otras bacterias coliformes [2]. Por lo tanto, en este trabajo se estudia si el velo mantiene esta capacidad una vez incorporado en el composite. Los composites se han colocado en vasos de vidrio en contacto con 100 mL de agua inoculada artificialmente con bacterias durante 24 h. En algunas pruebas, los vasos han sido irradiados con luz UV, y en otras, se mantuvieron en oscuridad. Transcurrido este periodo, el agua en contacto con los composites ha sido filtrada a través de una membrana de 0,45 μm de diámetro de poro, validada según ISO 7704:1985, la cual se incubada durante diferentes tiempos (24 y 96 h) a 36 ± 2 º C.
La figura 4 muestra la apariencia final de las membranas que se han utilizado para filtrar el agua en contacto con los composites después de 24 h y 96 h de incubación.
Después de 96 h de incubación, las membranas que estaban en contacto con los distintos composites, pero donde los composites no habían sido expuestos a radiación UV durante este tiempo de contacto con las bacterias, presentaban colonias de bacterias de color púrpura, indicando la acción simultánea de las enzimas presentes en E. coli y bacterias coliformes. Cuando el estudio se realiza bajo radiación UV durante el tiempo de contacto del agua inoculada artificialmente con el composite, se observa en las membranas una reducción significativa en la concentración de bacterias. Sin embargo, la membrana que se usó para filtrar el agua en contacto con los materiales compuestos donde se encontraba el velo modificado con 25% de TiO2, no presentó ninguna bacteria cuando el compuesto es irradiado con luz UV. Este hecho confirma el efecto fotocatalítico de los composites y se puede explicar por la presencia de una parte de los velos en la superficie exterior de los composites, la cual tiene un contacto directo con las bacterias.
Las imágenes de SEM, mostradas en la figura 5, confirman que el velo modificado con 25% de TiO2 puede posicionarse en dos zonas diferentes del composite, en la parte externa de los composites o bien encontrase cubiertos por unos 20 μm de resina. Este posicionamiento se produce de forma aleatoria y es consecuencia del proceso de infusión empleado en la preparación de los composites.
(a)
(b)
4 Conclusiones
El presente trabajo investiga el efecto de incorporar velos de PA6 electrohilados modificados con un 25% en peso de nanopartículas de TiO2 en el comportamiento mecánico y funcional de materiales compuestos de fibra de carbono / epoxi fabricados mediante infusión al vacío.
Los resultados muestran que la incorporación de velos de nanofibras electrohiladas de PA6 aumenta las propiedades mecánicas de los composites. La incorporación de un único velo entre las láminas de fibra de carbono, en un composite modelo preparado con dos únicas capas de fibra de carbono, aumenta la resistencia a la flexión del composite un 19,7% cuando se incorpora el velo de PA6 y un 24,6% cuando se incorpora el velo modificado con 25% de nanopartículas de TiO2. Dado que el grosor de los velos no modificado y modificado es similar, 11 µm y 20 µm respectivamente, el aumento en la resistencia a la flexión de los materiales compuestos se ha atribuido a la capacidad de los velos de cambiar la trayectoria de la grieta. Cabe resaltar, que las propiedades de los composites con ambos velos son similares, pese a que se esperaba que las nanopartículas mejoraran las propiedades del velo, y por consiguiente, las de los composites donde van incorporados. Esto podría deberse al hecho de que las nanopartículas de TiO2 afectan a la cristalización de la PA6, reduciendo las propiedades mecánicas de las nanofibras, ya que los cristales de fase γ (prevalentes en el velo modificado con TiO2) son menos estables que los cristales de fase α (prevalentes en el velo no modificado). Además, también podría darse un efecto negativo de los velos modificados en la estructura de reticulación de la red de epoxi-amina, ya que el análisis mediante DMTA muestra la presencia de redes más heterogéneas para los composites con velos modificados con un 25% en peso TiO2. Para los composites conceptuales preparados con tres velos, los resultados muestras que los velos en las caras externas no contribuyen a una mejora de las propiedades de flexión. Con respecto al comportamiento de fractura, los valores GIC para los materiales compuestos con velos fueron más altos que para los del composite referencia, aproximadamente 20% y 14% para los composites con un velo de PA6 no modificado y modificado con 25% en peso nanopartículas de TiO2, respectivamente; mientras que el valor GIIC de los composites con velos fueron similares a los valores de los composites de referencia. En todos los casos, la presencia de las nanopartículas de TiO2 tiene poca influencia en la resistencia a la fractura de los composites.
Por otro lado, la incorporación de los velos de nanofibras electrohiladas de PA6 modificadas con 25% en peso de nanopartículas de TiO2 en la cara externa de los composites, se ha demostrado que es un método eficaz para obtener composites con propiedades antibacterianas frente a E. coli y otras bacterias coliformes cuando se irradian con luz UV, debido al efecto fotocatalítico de las nanopartículas de TiO2. Esto se logra gracias a la presencia de los velos en diversas áreas de la superficie exterior de los materiales compuestos, como ha sido confirmado por SEM. La posibilidad de desarrollar materiales compuestos antibacterianos de una forma sencilla y sin necesidad de modificar la totalidad de la matriz epoxídica permitirá la expansión de estos composites a aplicaciones donde estén en contacto con microorganismos, como en aplicaciones marinas donde la presencia de incrustaciones es un grave problema económico y de seguridad, o en aplicaciones relacionadas con el contacto con personas, como el sector del transporte.
Agradecimientos
Los autores agradecen al gobierno Vasco la financiació de este trabajo a través del programa Elkartek “ACTIMAT 2018-2019” (KK-2018/00099) y a los grupos de investigación del sistema universitario vasco (IT718-13).
Referencias
[1] C.Monteserín, M.Blanco, N.Murillo, A.Pérez-Márquez, J.Maudes, J.Gayoso, J.M.Laza, E.Aranzabe, J.L.Vilas, Polymers, 10, pág. 1190-1206 (2018).
https://doi.org/10.3390/polym10111190
[2] M.Blanco, M.López, R.Fernández, L.Martín, C.C.Riccardi, I.Mondragon, J Therm Anal Calorim, 97, pág. 969–978 (2009).
https://doi.org/10.1007/s10973-009-0174-5
[3] M.S.Radue, G.M.Odegard, Composites Science and Technology, 166, pág. 20-26 (2018).
https://doi.org/10.1016/j.compscitech.2018.03.006
[4] M.Blanco, C.Monteserín, A.Angulo, A.Pérez-Márquez, J.Maudes, N.Murillo, E.Aranzabe, L.Ruiz-Rubio, J.L.Vilas, Polymers, 11, 5, pág. 747-757 (2019).
https://doi.org/10.3390/polym11050747
[5] R.Neppalli, V.Causin, E.M.Benetti, S.S.Ray, A.Esposito, S.Wanjale, Eur Polym J, 50, pág. 78-86 (2014).
Document information
Published on 21/06/22
Accepted on 19/06/22
Submitted on 19/06/22
Volume 05 - Comunicaciones Matcomp19 (2021), Issue Núm. 3 - Procesos de Fabricación – Materiales Funcionales., 2022
DOI: 10.23967/r.matcomp.2022.06.027
Licence: Other
Share this document
Keywords
claim authorship
Are you one of the authors of this document?